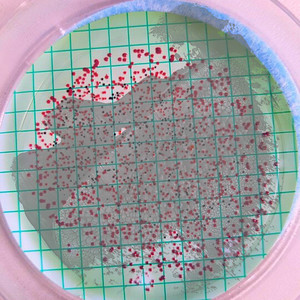
Green Tempos
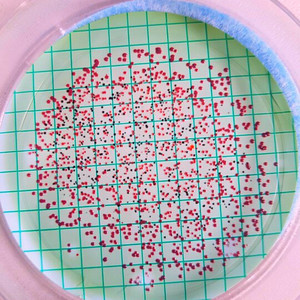
Growling Excuses

当前位置:首页 >> CHRONIC PAIN >> 歌曲列表 第页
CHRONIC PAIN
此歌手暂无简介
热门歌曲
更多..
-
Switch Off、CHRONIC PAIN 1.58 MB 01:43
-
Switch Off、CHRONIC PAIN 2.81 MB 03:04
-
Switch Off、CHRONIC PAIN、Skido 3.55 MB 03:52
-
CHRONIC PAIN 1.42 MB 01:32
-
CHRONIC PAIN 3.91 MB 04:16
-
CHRONIC PAIN 1.51 MB 01:38
-
CHRONIC PAIN 1.89 MB 02:04
-
CHRONIC PAIN 2.96 MB 03:13